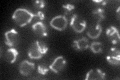
YNL081C

View description
Putative mitochondrial ribosomal protein of the small subunit, has similarity to E. coli S13 ribosomal protein; participates in controlling sporulation efficiency
Localization:
Intensity:
Fold change:
Significance:
-
C’ GFP library in SD
mitochondria52.76 -
N' NOP1pr-GFP in SD

punctate22.366 -
N' TEF2pr-mCherry in SD

below threshold0 -
N' NATIVEpr-GFP in SD

below threshold19.161 -
N' TEF2pr-VC and Cyto-VN in SD

#N/A0 -
C’ GFP library in SD+DTT

mitochondria57.861.09No -
C’ GFP library in SD+H2O2

vacuole34.790.65No -
C’ GFP library in Starvation Media

mitochondria69.961.32No -
C’ GFP library on the background of Pup2-DaMP

mitochondria -
C’ GFP library on the background of CCT mutant

mitochondria45.0550.853791No
